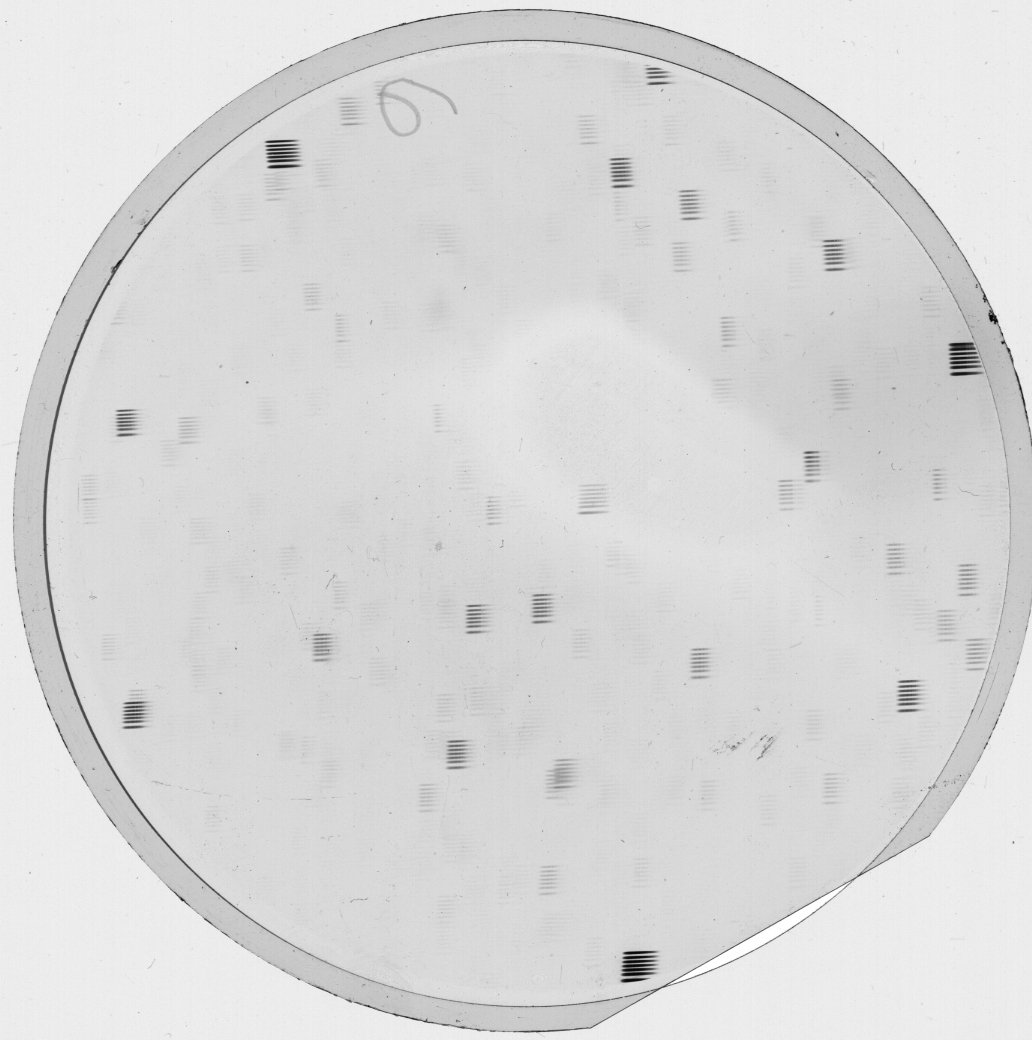

Plate from Kleiner Schmidt-Spiegel II (Hamburg)
Preview
KS00199_pre.jpg

Envelope
(link)

| Applause ID: | dr.3/plates/110_69825 |
| Archive: | Kleiner Schmidt-Spiegel II (Hamburg) |
| Plate number in archive: | KS00199 |
| Institute: | Hamburger Sternwarte |
| Observer name: | Eberlein |
| Observer notes: | |
| Miscellaneous notes: | +6x50s, Fokusaufnahme |
| Bibcode of related paper: | |
| Plate series: | |
| Dispersion: | |
| Plate development information: | |
| Plate quality: | |
| Plate notes: | |
| Plate format: | cifi9 cm |
| Emulsion: | Kodak Oa-O |
| Original recorded date: | 1955-12-11 |
| Number of exposures: | 7 |
| Observatory name: | Hamburger Sternwarte |
| Observatory site name: | Hamburg-Bergedorf; Germany |
| East longitude of the observing site: | 10.242 deg |
| Latitude of the observing site: | 53.482 deg |
| Elevation of the observatory site: | 41.0 m |
| Clear aperture of the telescope: | 0.36 m |
| Focal length of the telescope: | 0.62 m |
| Plate scale of the telescope: | 330.0 arcsec/mm |
| Instrument name: | |
| Observation filter: | |
| Observation method code (following WFPDB): | |
| Observation prism used: | 5-deg Obj.-Prisma (SS) |
| Used grating: | |
| Air temperature: | |
| Calmness (seeing conditions): | |
| Sharpness: | |
| Transparency: | |
| Notes on sky conditions: |
